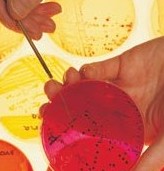
taj_clinical trials2

Before
a pharmaceutical company can initiate testing in
humans, it must conduct extensive preclinical or
laboratory research. This research typically
involves years of experiments in animal and human
cells. The compounds are also extensively tested in
animals. If this stage of testing is successful, a
pharmaceutical company provides this data to the
Food and Drug Administration (FDA), requesting
approval to begin testing the drug in humans. This
is called an Investigational New Drug application (IND). Before
a pharmaceutical company can initiate testing in
humans, it must conduct extensive preclinical or
laboratory research. This research typically
involves years of experiments in animal and human
cells. The compounds are also extensively tested in
animals. If this stage of testing is successful, a
pharmaceutical company provides this data to the
Food and Drug Administration (FDA), requesting
approval to begin testing the drug in humans. This
is called an Investigational New Drug application (IND). |
|
| The clinical testing of experimental
drugs is normally done in three phases, each
successive phase involving a larger number of
people. Once the FDA has granted a New Drug Approval
(NDA), pharmaceutical companies also conduct post
marketing or late phase three/phase four studies. |
|
| Phase I
studies are primarily concerned with
assessing the drug's safety. This initial phase of
testing in humans is done in a small number of
healthy volunteers (20 to 100), who are usually paid
for participating in the study. The study is
designed to determine what happens to the drug in
the human body--how it is absorbed, metabolized, and
excreted. A phase I study will investigate side
effects that occur as dosage levels are increased.
This initial phase of testing typically takes
several months. About 70 percent of experimental
drugs pass this initial phase of testing. |
|
Once a drug has been shown to be
safe, it must be tested for efficacy. This second phase of testing may last from
several months to two years, and involve up to
several hundred patients. Most
phase II studies are randomized
trials. One group of patients will receive the
experimental drug, while a second "control" group
will receive a standard treatment or placebo. Often
these studies are "blinded"--neither the patients
nor the researchers know who is getting the
experimental drug. In this manner, the study can
provide the pharmaceutical company and the FDA
comparative information about the relative safety of
the new drug, and its effectiveness. Only about
one-third of experimental drugs successfully
complete both phase I and phase II studies.
efficacy. This second phase of testing may last from
several months to two years, and involve up to
several hundred patients. Most
phase II studies are randomized
trials. One group of patients will receive the
experimental drug, while a second "control" group
will receive a standard treatment or placebo. Often
these studies are "blinded"--neither the patients
nor the researchers know who is getting the
experimental drug. In this manner, the study can
provide the pharmaceutical company and the FDA
comparative information about the relative safety of
the new drug, and its effectiveness. Only about
one-third of experimental drugs successfully
complete both phase I and phase II studies. |
|
| In a phase
III study, a drug is tested in several
hundred to several thousand patients. This
large-scale testing provides the pharmaceutical
company and the FDA with a more thorough
understanding of the drug's effectiveness, benefits,
and the range of possible adverse reactions. Most
phase III studies are randomized and blinded trials.
Phase III studies typically last several years.
Seventy to 90 percent of drugs that enter phase III
studies successfully complete this phase of testing.
Once a phase III study is successfully completed, a
pharmaceutical company can request FDA approval for
marketing the drug. |
|
| In late
phase III/phase IV studies,
pharmaceutical companies have several objectives:
(1) studies often compare a drug with other drugs
already in the market; (2) studies are often
designed to monitor a drug's long-term effectiveness
and impact on a patient's quality of life; and (3)
many studies are designed to determine the
cost-effectiveness of a drug therapy relative to
other traditional and new therapies. |
|
 People
participate in clinical research for a variety of
reasons. People who volunteer for phase II and phase
III trials can gain access to promising drugs long
before these compounds are approved for the
marketplace. They typically will get excellent care
from the physicians during the course of the study.
This care also may be free. The patient's rights and
safety are protected in two important ways. First,
any physician awarded a research grant by a
pharmaceutical company or the NIH must obtain
approval to conduct the study from an Institutional
Review Board. The review board, which is usually
composed of physicians and lay people, is charged
with examining the study's protocol to ensure that
the patient's rights are protected, and that the
study does not present an undue or unnecessary risk
to the patient. Second, anyone participating in a
clinical trial in the United States is required to
sign an "informed consent" form. This form details
the nature of the study, the risks involved, and
what may happen to a patient in the study. The
informed consent tells patients that they have a
right to leave the study at any time. Patients
considering participating in clinical research
should talk about it with their physicians and
medical caregivers. They also should seek to
understand the credentials and experience of the
individuals and the facility involved in conducting
the study. People
participate in clinical research for a variety of
reasons. People who volunteer for phase II and phase
III trials can gain access to promising drugs long
before these compounds are approved for the
marketplace. They typically will get excellent care
from the physicians during the course of the study.
This care also may be free. The patient's rights and
safety are protected in two important ways. First,
any physician awarded a research grant by a
pharmaceutical company or the NIH must obtain
approval to conduct the study from an Institutional
Review Board. The review board, which is usually
composed of physicians and lay people, is charged
with examining the study's protocol to ensure that
the patient's rights are protected, and that the
study does not present an undue or unnecessary risk
to the patient. Second, anyone participating in a
clinical trial in the United States is required to
sign an "informed consent" form. This form details
the nature of the study, the risks involved, and
what may happen to a patient in the study. The
informed consent tells patients that they have a
right to leave the study at any time. Patients
considering participating in clinical research
should talk about it with their physicians and
medical caregivers. They also should seek to
understand the credentials and experience of the
individuals and the facility involved in conducting
the study. |
|
Clinical trials that are
well-designed and well-executed are the best
approach for eligible participants to:
- Play an active role in their own health care.
- Gain access to new research treatments before
they are widely available.
- Obtain expert medical care at leading health
care facilities during the trial.
- Help others by contributing to medical
research.
|
|
There are risks to clinical trials.
- There may be unpleasant, serious or even
life-threatening side effects to experimental
treatment.
- The experimental treatment may not be
effective for the participant.
- The protocol may require more of their time
and attention than would a non-protocol treatment,
including trips to the study site, more
treatments, hospital stays or complex dosage
requirements.
|
|


